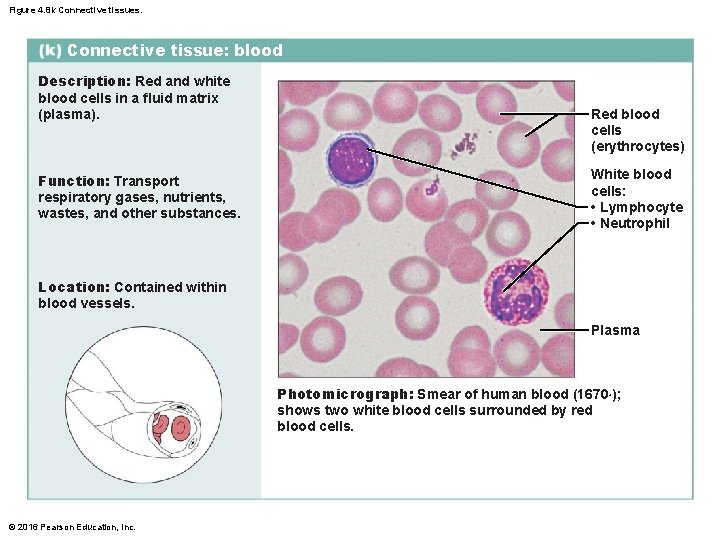
Figure 4. 8 k Connective tissues. Connective tissue: blood Description: Red and white blood

Figure 4 1 Overview of four basic tissue

Figure 4. 1 Overview of four basic tissue types: epithelial, connective, muscle, and nervous tissues. Nervous tissue: Internal communication • Brain • Spinal cord • Nerves Muscle tissue: Contracts to cause movement • Muscles attached to bones (skeletal) • Muscles of heart (cardiac) • Muscles of walls of hollow organs (smooth) Epithelial tissue: Forms boundaries between different environments, protects, secretes, absorbs, filters • Lining of digestive tract organs and other hollow organs • Skin surface (epidermis) Connective tissue: Supports, protects, binds other tissues together • Bones • Tendons • Fat and other soft padding tissue © 2016 Pearson Education, Inc.

Figure 4. 2 a Classification of epithelia. Apical surface Basal surface Simple Apical surface Basal surface Stratified Classification based on number of cell layers. © 2016 Pearson Education, Inc.

Figure 4. 2 b Classification of epithelia. Squamous Cuboidal Columnar © 2016 Pearson Education, Inc. Classification based on cell shape.

Classification of Epithelia (cont. ) • 4 types of Simple epithelia – Involved in absorption, secretion, or filtration processes Apical surface Basal surface © 2016 Pearson Education, Inc. Simple

Figure 4. 3 a Epithelial tissues. Simple squamous epithelium Description: Single layer of flattened cells with disc-shaped central nuclei and sparse cytoplasm; the simplest of the epithelia. Air sacs of lung tissue Nuclei of squamous epithelial cells Function: Allows materials to pass by diffusion and filtration in sites where protection is not important; secretes lubricating substances in serosae. Location: Kidney glomeruli; air sacs of lungs; lining of heart, blood vessels, and lymphatic vessels; lining of ventral body cavity (serosae). © 2016 Pearson Education, Inc. Photomicrograph: Simple squamous epithelium forming part of the alveolar (air sac) walls (140×).

Figure 4. 3 b Epithelial tissues. Simple cuboidal epithelium Description: Single layer of cubelike cells with large, spherical central nuclei. Simple cuboidal epithelial cells Nucleus Function: Secretion and absorption. Basement membrane Location: Kidney tubules; ducts and secretory portions of small glands; ovary surface. Connective tissue Photomicrograph: Simple cuboidal epithelium in kidney tubules (430×). © 2016 Pearson Education, Inc.

Figure 4. 3 c Epithelial tissues. Simple columnar epithelium Description: Single layer of tall cells with round to oval nuclei; many cells bear microvilli, some bear cilia; layer may contain mucus-secreting unicellular glands (goblet cells). Microvilli Simple columnar epithelial cell Function: Absorption; secretion of mucus, enzymes, and other substances; ciliated type propels mucus (or reproductive cells) by ciliary action. Location: Nonciliated type lines most of the digestive tract (stomach to rectum), gallbladder, and excretory ducts of some glands; ciliated variety lines small bronchi, uterine tubes, and some regions of the uterus. © 2016 Pearson Education, Inc. Mucus of goblet cell Photomicrograph: Simple columnar epithelium of the small intestine mucosa (640×).

Figure 4. 3 d Epithelial tissues. Pseudostratified columnar epithelium Description: Single layer of cells of differing heights, some not reaching the free surface; nuclei seen at different levels; may contain mucus-secreting cells and bear cilia. Goblet cell (contains mucus) Cilia Pseudostratified epithelial layer Function: Secrete substances, particularly mucus; propulsion of mucus by ciliary action. Location: Nonciliated type in males’ sperm-carrying ducts and ducts of large glands; ciliated variety lines the trachea, most of the upper respiratory tract. Trachea © 2016 Pearson Education, Inc. Photomicrograph: Pseudostratified ciliated columnar epithelium lining the human trachea (780×). Basement membrane

Classification of Epithelia (cont. ) • Four types of Stratified epithelial tissues – Involve two or more layers of cells – New cells regenerate from below • Basal cells divide and migrate toward surface – Durable Apical surface Basal surface © 2016 Pearson Education, Inc. Stratified

Figure 4. 3 e Epithelial tissues. Stratified squamous epithelium Description: Thick membrane composed of several cell layers; basal cells are cuboidal or columnar and metabolically active; surface cells are flattened (squamous); in the keratinized type, the surface cells are full of keratin and dead; basal cells are active in mitosis and produce the cells of the more superficial layers. Stratified squamous epithelium Nuclei Basement membrane Connective tissue Function: Protects underlying tissues in areas subjected to abrasion. Location: Nonkeratinized type forms the moist linings of the esophagus, mouth, and vagina; keratinized variety forms the epidermis of the skin, a dry membrane. © 2016 Pearson Education, Inc. Photomicrograph: Stratified squamous epithelium lining the esophagus (285×).

Figure 4. 3 f Epithelial tissues. Transitional epithelium Description: Resembles both stratified squamous and stratified cuboidal; basal cells cuboidal or columnar; surface cells dome shaped or squamouslike, depending on degree of organ stretch. Transitional epithelium Function: Stretches readily, permits stored urine to distend urinary organ. Location: Lines the ureters, bladder, and part of the urethra. © 2016 Pearson Education, Inc. Basement membrane Photomicrograph: Transitional epithelium lining the bladder, relaxed state (360×); note the bulbous, or rounded, appearance of the cells at the surface; these cells flatten and elongate when the bladder fills with urine. Connective tissue

Table 4. 1 -1 Comparison of Classes of Connective Tissues © 2016 Pearson Education, Inc.

Table 4. 1 -2 Comparison of Classes of Connective Tissues (continued) © 2016 Pearson Education, Inc.

Figure 4. 7 Areolar connective tissue: A prototype (model) connective tissue. Cell types Extracellular matrix Ground substance Macrophage Fibers • Collagen fiber • Elastic fiber • Reticular fiber Fibroblast Lymphocyte Fat cell Mast cell Neutrophil © 2016 Pearson Education, Inc. Capillary

Figure 4. 8 a Connective tissues. Connective tissue proper: loose connective tissue, areolar Description: Gel-like matrix with all three fiber types; cells: fibroblasts, macrophages, mast cells, and some white blood cells. Elastic fibers Function: Wraps and cushions organs; its macrophages phagocytize bacteria; plays important role in inflammation; holds and conveys tissue fluid. Ground substance Fibroblast nuclei Location: Widely distributed under epithelia of body, e. g. , forms lamina propria of mucous membranes; packages organs; surrounds capillaries. Epithelium Lamina propria © 2016 Pearson Education, Inc. Collagen fibers Photomicrograph: Areolar connective tissue, a soft packaging tissue of the body (340×).

Figure 4. 8 b Connective tissues. Connective tissue proper: loose connective tissue, adipose Description: Matrix as in areolar, but very sparse; closely packed adipocytes, or fat cells, have nucleus pushed to the side by large fat droplet. Nucleus of adipose (fat) cell Function: Provides reserve food fuel; insulates against heat loss; supports and protects organs. Fat droplet Location: Under skin in subcutaneous tissue; around kidneys and eyeballs; within abdomen; in breasts. Adipose tissue Mammary glands © 2016 Pearson Education, Inc. Photomicrograph: Adipose tissue from the subcutaneous layer under the skin (350×).

Figure 4. 8 c Connective tissues. Connective tissue proper: loose connective tissue, reticular Description: Loose network of reticular fibers in a gel-like ground substance; reticular cells lie on the network. Function: Fibers form a soft internal skeleton (stroma) that supports other cell types including white blood cells, mast cells, and macrophages. White blood cell (lymphocyte) Reticular fibers Location: Lymphoid organs (lymph nodes, bone marrow, and spleen). Photomicrograph: Dark-staining network of reticular connective tissue fibers forming the internal skeleton of the spleen (350×). Spleen © 2016 Pearson Education, Inc.

Figure 4. 8 d Connective tissues. Connective tissue proper: dense connective tissue, dense regular Description: Primarily parallel collagen fibers; a few elastic fibers; major cell type is the fibroblast. Collagen fibers Function: Attaches muscles to bones or to muscles; attaches bones to bones; withstands great tensile stress when pulling force is applied in one direction. Nuclei of fibroblasts Location: Tendons, most ligaments, aponeuroses. Shoulder joint Ligament Tendon © 2016 Pearson Education, Inc. Photomicrograph: Dense regular connective tissue from a tendon (430×).

Figure 4. 8 e Connective tissues. Connective tissue proper: dense connective tissue, dense irregular Description: Primarily irregularly arranged collagen fibers; some elastic fibers; fibroblast is the major cell type. Nuclei of fibroblasts Function: Withstands tension exerted in many directions; provides structural strength. Location: Fibrous capsules of organs and of joints; dermis of the skin; submucosa of digestive tract. Collagen fibers Shoulder joint Photomicrograph: Dense irregular connective tissue from the fibrous capsule of a joint (430×). Fibrous joint capsule © 2016 Pearson Education, Inc.

Figure 4. 8 f Connective tissues. Connective tissue proper: dense connective tissue, elastic Description: Dense regular connective tissue containing a high proportion of elastic fibers. Function: Allows tissue to recoil after stretching; maintains pulsatile flow of blood through arteries; aids passive recoil of lungs following inspiration. Elastic fibers Location: Walls of large arteries; within certain ligaments associated with the vertebral column; within the walls of the bronchial tubes. Photomicrograph: Elastic connective tissue in the wall of the aorta (250×). Aorta Heart © 2016 Pearson Education, Inc.

Figure 4. 8 g Connective tissues. Cartilage: hyaline Description: Amorphous but firm matrix; collagen fibers form an imperceptible network; chondroblasts produce the matrix and when mature (chondrocytes) lie in lacunae. Chondrocyte in lacuna Function: Supports and reinforces; serves as resilient cushion; resists compressive stress. Matrix Location: Forms most of the embryonic skeleton; covers the ends of long bones in joint cavities; forms costal cartilages of the ribs; cartilages of the nose, trachea, and larynx. Photomicrograph: Hyaline cartilage from a costal cartilage of a rib (470×). Costal cartilages © 2016 Pearson Education, Inc.

Figure 4. 8 h Connective tissues. Cartilage: elastic Description: Similar to hyaline cartilage, but more elastic fibers in matrix. Chondrocyte in lacuna Function: Maintains the shape of a structure while allowing great flexibility. Matrix Location: Supports the external ear (pinna); epiglottis. Photomicrograph: Elastic cartilage from the human ear pinna; forms the flexible skeleton of the ear (800×). © 2016 Pearson Education, Inc.

Figure 4. 8 i Connective tissues. Cartilage: fibrocartilage Description: Matrix similar to but less firm than that in hyaline cartilage; thick collagen fibers predominate. Function: Tensile strength allows it to absorb compressive shock. Chondrocytes in lacunae Location: Intervertebral discs; pubic symphysis; discs of knee joint. Collagen fiber Intervertebral discs Photomicrograph: Fibrocartilage of an intervertebral disc (125×). Special staining produced the blue color seen. © 2016 Pearson Education, Inc.

Figure 4. 8 j Connective tissues. Others: bone (osseous tissue) Description: Hard, calcified matrix containing many collagen fibers; osteocytes lie in lacunae. Very well vascularized. Central canal Lacunae Function: Supports and protects (by enclosing); provides levers for the muscles to act on; stores calcium and other minerals and fat; marrow inside bones is the site for blood cell formation (hematopoiesis). Lamella Location: Bones Photomicrograph: Cross-sectional view of bone (125×). © 2016 Pearson Education, Inc.
Figure 4. 8 k Connective tissues. Connective tissue: blood Description: Red and white blood cells in a fluid matrix (plasma). Function: Transport respiratory gases, nutrients, wastes, and other substances. Red blood cells (erythrocytes) White blood cells: • Lymphocyte • Neutrophil Location: Contained within blood vessels. Plasma Photomicrograph: Smear of human blood (1670×); shows two white blood cells surrounded by red blood cells. © 2016 Pearson Education, Inc.

Figure 4. 9 a Muscle tissues. Skeletal muscle Description: Long, cylindrical, multinucleate cells; obvious striations. Part of muscle fiber (cell) Function: Voluntary movement; locomotion; manipulation of the environment; facial expression; voluntary control. Nuclei Location: In skeletal muscles attached to bones or occasionally to skin. Striations Photomicrograph: Skeletal muscle (440×). Notice the obvious banding pattern and the fact that these large cells are multinucleate. © 2016 Pearson Education, Inc.

Figure 4. 9 b Muscle tissues. Cardiac muscle Description: Branching, striated, generally uninucleate cells that interdigitate at specialized junctions (intercalated discs). Intercalated discs Function: As it contracts, it propels blood into the circulation; involuntary control. Striations Nucleus Location: The walls of the heart. Photomicrograph: Cardiac muscle (475×); notice the striations, branching of cells, and the intercalated discs. © 2016 Pearson Education, Inc.

Figure 4. 9 c Muscle tissues. Smooth muscle Description: Spindle-shaped (elongated) cells with central nuclei; no striations; cells arranged closely to form sheets. Nuclei Function: Propels substances or objects (foodstuffs, urine, a baby) along internal passageways; involuntary control. Location: Mostly in the walls of hollow organs. Smooth muscle cell Photomicrograph: Sheet of smooth muscle from the digestive tract (500×). © 2016 Pearson Education, Inc.

Figure 4. 10 Nervous tissue Description: Neurons are branching cells; cell processes that may be quite long extend from the nucleus-containing cell body; also contributing to nervous tissue are nonexcitable supporting cells. Neuron processes Cell body Nuclei of supporting cells Axon Dendrites Cell body of a neuron Function: Neurons transmit electrical signals from sensory receptors and to effectors (muscles and glands); supporting cells support and protect neurons. Neuron processes Location: Brain, spinal cord, and nerves. Photomicrograph: Neurons (350×) © 2016 Pearson Education, Inc.

Figure 4. 11 a Classes of membranes. Cutaneous membrane The cutaneous membrane (the skin) covers the body surface. Cutaneous membrane (skin) © 2016 Pearson Education, Inc.

Figure 4. 11 b Classes of membranes. Mucous membranes line body cavities that are open to the exterior. Mucosa of nasal cavity Mucosa of mouth Esophagus lining Mucosa of lung bronchi © 2016 Pearson Education, Inc.

Figure 4. 11 c Classes of membranes. Serous membranes line body cavities that are closed to the exterior. Parietal pleura Visceral pleura Parietal Visceral pericardium © 2016 Pearson Education, Inc. Parietal peritoneum Visceral peritoneum
- Slides: 32